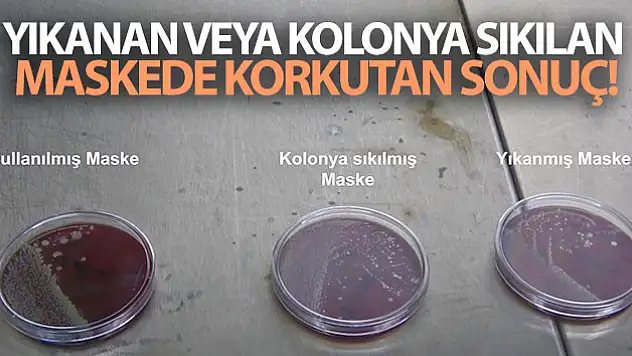
Yıkanan veya kolonya sıkılan maskede korkutan sonuç

korku
Korku haberleri ve son dakika gelişmelerine ait tüm haberleri listeleyin.

Edremit’te korkutan yangın

15 kişinin öldüğü Doğanlar Apartmanı ile ilgili korkunç iddia

Küresel iklim değişikliği ve kuraklık korkutuyor; Van Gölü’nde su kaybı endişesi

İş yerinde korkutan yangın

Özalp ilçesinde korkutan yangın

Afganistan'dan korkutan görüntü

Altında korkulan olacak mı

Van Gölü’nde karaya oturan tekne korkuttu

Koronavirüste korkutan ölüm: Alfa ve Beta varyantı aynı anda bulaşmış

Kuş cennetinde korkutan yangın

Van Gölü’nde buharlaşma korkunç seviyelere ulaştı

Avrupa 1 Temmuz'da başlıyor... Tüm dünyayı korkutan uyarı: Kaos çıkaracak

Korkutan tablo! Can kaybında dünya rekoru

Komşuda Bayraktar TB2 korkusu: Ucuz ve ölümcül

Van’da korkutan yangın

Japon bilim insanlarından korkutan araştırma

Çipten sonra şimdi de lastik krizi! Elun Musk'tan korkutan açıklama

Bakan Koca korkutan oranı paylaştı: Yüzde 80! Ramazanda kapanma olacak mı?

Rehavete kapılan Van’da vaka artışı korkuttu

Van’da korkutan yangın

Özalp ilçesinde korkutan yangın

Siirt'te korkunç anlar! 3 kişiye kurşun yağdırdı

Van’da korkutan yangın

İran’dan korkutan mutasyonlu virüs açıklaması

Erciş’te korkutan yangın

Edremit’te korkutan yangın
Yıkanan veya kolonya sıkılan maskede korkutan sonuç

İngiltere'den korkutan koronavirüs uyarısı: En kötüsü gelecek!

Meteorolojinin korkutan kuraklık haritası: Orta Karadeniz olağanüstü ve çok şiddetli kuraklık riskinde

Malatya'da korkutan deprem!

Koronavirüs salgınıyla mücadelede doluluk oranları korkuttu

Beyaz Saray Covid-19 Danışmanı Dr. Fauci'den korkutan açıklama

Koronavirüs korkusu her şeyi geride bıraktı

Mutasyona uğrayan koronayla ilgili korkutan gelişme

Bakanın örnek gösterdiği Tekirdağ için korkutan harita

Halk pazarında korkutan yangın

KORKU ÇAĞI

TÜRKİYE'DE ÇALIŞANLARIN YÜZDE 64'Ü İŞİNİ KAYBETMEKTEN KORKUYOR

Korkutan yangın itfaiye ekiplerinin müdahalesiyle söndürüldü

Malatya'da deprem korkuttu